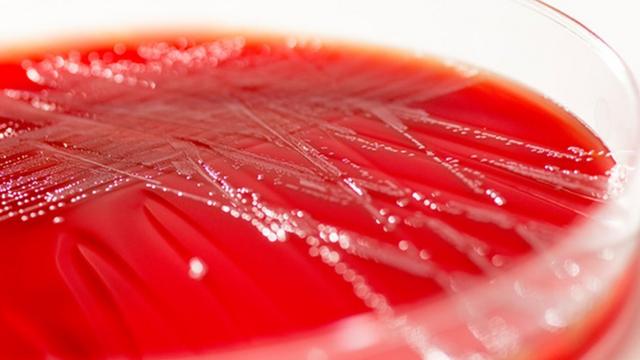
Bactéria

Conheça o superantibiótico capazbet365 não carrega no chromecombater bactérias resistentes:bet365 não carrega no chrome

Crédito, SPL
O ERV é uma das bactérias mais resistentes atualmente
bet365 não carrega no chrome Cientistas americanos reformularam um antibiótico vitalbet365 não carrega no chromeuma tentativabet365 não carrega no chromeacabar com uma das superbactérias mais ameaçadoras do mundo.
De acordo com o estudo do Institutobet365 não carrega no chromePesquisas Scripps, a nova versão da vancomicina foi desenvolvida para ser ultrarresistente e parece ser mil vezes mais potente do que a anterior.
A pesquisa, publicada na revista científica PNAS, sugere que a nova droga combate as bactériasbet365 não carrega no chrometrês formas diferentes, reduzindo as chancesbet365 não carrega no chromedefesa.
Os pesquisadores afirmam que o medicamento - ainda não testadobet365 não carrega no chromeanimais ou humanos - estará disponível para uso dentrobet365 não carrega no chromecinco anos caso seja aprovadobet365 não carrega no chromenovos testes.
O combate às superbactérias

Crédito, SPL
A bactéria preocupa médicos e é encontradabet365 não carrega no chromehospitais
Especialistas já vêm alertando que estamos nos aproximando da "era pós-antibióticos", na qual algumas infecções podem se tornar intratáveis.
Um dessas infecções difíceisbet365 não carrega no chromecombater e que preocupa médicos é a causada pelo enterococcus resistente à vancomicina (ERV). Ela é encontradabet365 não carrega no chromehospitais, pode provocar feridas perigosas e infecções na corrente sanguínea e é considerada pela OMS (Organização Mundial da Saúde) como uma das bactérias resistentes a medicamentos que mais ameaça a saúde humana.
Alguns antibióticos ainda funcionam contra o ERV, mas a vancomicina, criada há 60 anos, já é impotente para o tratamento. Por isso, os cientistas do Instituto Scripps estão tentando renovar o antibiótico para tentar restaurar abet365 não carrega no chromecapacidadebet365 não carrega no chromematar a bactéria.
Eles fizeram algumas mudanças estratégicas na estrutura molecular da droga antiga para torná-la mais eficazbet365 não carrega no chromeatacar a bactéria onde é necessário: na destruiçãobet365 não carrega no chromeparedes celulares.
Mais poderes
Três mudanças são particularmente importantes e aumentam a força e a durabilidade do medicamento.
"Nós fizemos uma mudança na molécula da droga que supera a atual resistência à vancomicina. Depois disso, adicionamos à molécula duas mudanças que, incorporadas a ela, criam duas novas formasbet365 não carrega no chromematar a bactéria. Então o antibiótico tem três mecanismos diferentesbet365 não carrega no chromematar a bactéria", explicou Dale Boger, responsável pela pesquisa.
Crédito, SPL
A bactéria é atacada com três mecanismos na nova versão da droga
"E a resistência a esse antibiótico pode ser muito difícilbet365 não carrega no chromeaparecer. Então a molécula é desenvolvida especificamente para lidar com o surgimento dessa resistência", completou.
O antibiótico modificado foi capazbet365 não carrega no chromematar amostrasbet365 não carrega no chromeERVbet365 não carrega no chromelaboratório e ainda assim reter quase todo o potencial depoisbet365 não carrega no chrome50 exposições à bactéria.
"Os organismos não conseguem lidar com o trabalhobet365 não carrega no chrometer que encontrar três formas diferentesbet365 não carrega no chromecombater e se livrar dos mecanismosbet365 não carrega no chromeação. Mesmo que encontrassem a solução para se livrarbet365 não carrega no chromeum deles, ainda restariam dois para matá-los. Os médicos podem usar essa versão modificada da vancomicina sem medobet365 não carrega no chromeque a resistência apareça", diz Boger.
Para o professor Nigel Brown, da Sociedadebet365 não carrega no chromeMicrobiologia, "esse modificação pode ser muito importante".
"A vancomicina é um antibiótico usado como último recursobet365 não carrega no chromealgumas infecções sérias. Havia muita preocupaçãobet365 não carrega no chromeque as bactérias estavam se tornando resistentes a ele."







